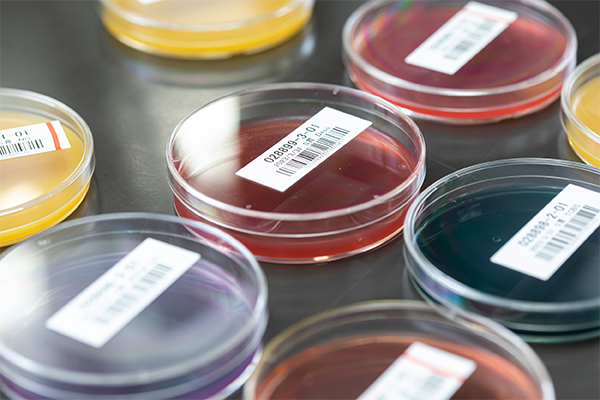

私たちの強みStrength
強み1 品質保証への取り組み
試験所認定
当社は試験所の国際規格
ISO/IEC17025:2017の認定試験所です
ISO/IEC17025:2017は“試験所認定”と呼ばれ、試験所が正確な測定結果を生み出す能力があるか、また独立・中立・公平性があるかを審査し、権威ある第三者認定機関が認定する規格で、当社は国際認定機関ペリージョンソンラボラトリーアクレディテーションインク(PJLA)(米国)により認定されました。
外部精度管理
外部精度管理(技能試験等)に積極的に参加し、技術を研鑚しています。
下記項目において、良好な結果(定量試験:Zスコア2以内、定性試験:正しい判定結果)が得られました。
| 主催 | 名称 |
|---|
| 一般財団法人日本食品分析センター | 微生物試験(一般生菌数・大腸菌群・大腸菌及び黄色ブドウ球菌) |
| 株式会社森永生化学研究所 | 食物アレルギー物質検査 精度管理サーベイ |
| 日本電子株式会社 | 食品中の残留農薬分析のための技能試験 2021 |
| 一般社団法人日本バイオテクノロジー認証機構 |
理化学試験(ヒスタミン)
理化学試験(栄養成分) |
強み2 微生物同定検査
開発・製造・ご指摘等の様ざまな段階や製造工程において、検査結果が思わしくないなど現状の改善が必要になる際に、微生物同定検査は原因追及の非常に有用な手段といえます。
当社は2011年よりMALDI-TOF(Matrix Assisted Laser Desorption Ionization-Time of Flight:マトリックス支援レーザー脱離イオン化 - 飛行時間型)の質量分析計を導入し、微生物の菌種の同定を行っています。
食品由来微生物の同定と微生物同定による原因箇所の特定など、製造現場への改善支援や、商品開発段階における課題解決となる検査分析のノウハウを持っています。
活用事例として、商品検査結果から採取した微生物と工場内の様々な箇所の拭き取り検体から採取した微生物のどれが近い種かを推測できるので、より緻密な発生源や経路の推定が可能となります。

Bruker社 Biotyperシステム
学会発表等
強み3 品質検査管理システム(LIMS※の構築)
※LIMSとは:laboratory information management systemの略称でラボ情報管理システムと呼ばれます
当社グループ(紀文食品)の微生物検査は、主力である魚肉練り製品や惣菜・麺状加工品など商品群が多岐にわたり、個々の商品ごとに検査項目も異なります。特に新商品開発・正月商品発売時期は非常に多検体の微生物検査が必要になります。そのため、検査の業務効率の向上・合理化を推進する必要がありました。
検査業務の効率を上げるために、2013年に微生物検査業務のDX化の先駆けとなる「品質検査管理システム」を構築しました。システムの導入により、手書きによるアナログな検査業務を全廃し、バーコード管理による検体情報の管理、検査結果の入力や集計、成績書発行までを一元管理できるようになり検査業務を大幅に効率化できました。
システム構築のメリット
- ① 帳票と手書きで管理していた検査品・シャーレを、バーコードで一元管理
- ② 手書きによる作業を全廃することで、検査品取違え、入力ミスの削減
- ③ 検査に伴う準備・事務作業の削減による業務効率化
- ④ データの一元管理によるセキュリティの向上
- ⑤ 検査依頼者側にとってはリアルタイムに検査進捗の確認と迅速な結果報告
検査品と検査器具(シャーレ等)をバーコードによる紐付け管理
※商品パッケージが写っている写真は2023年に撮影したものです